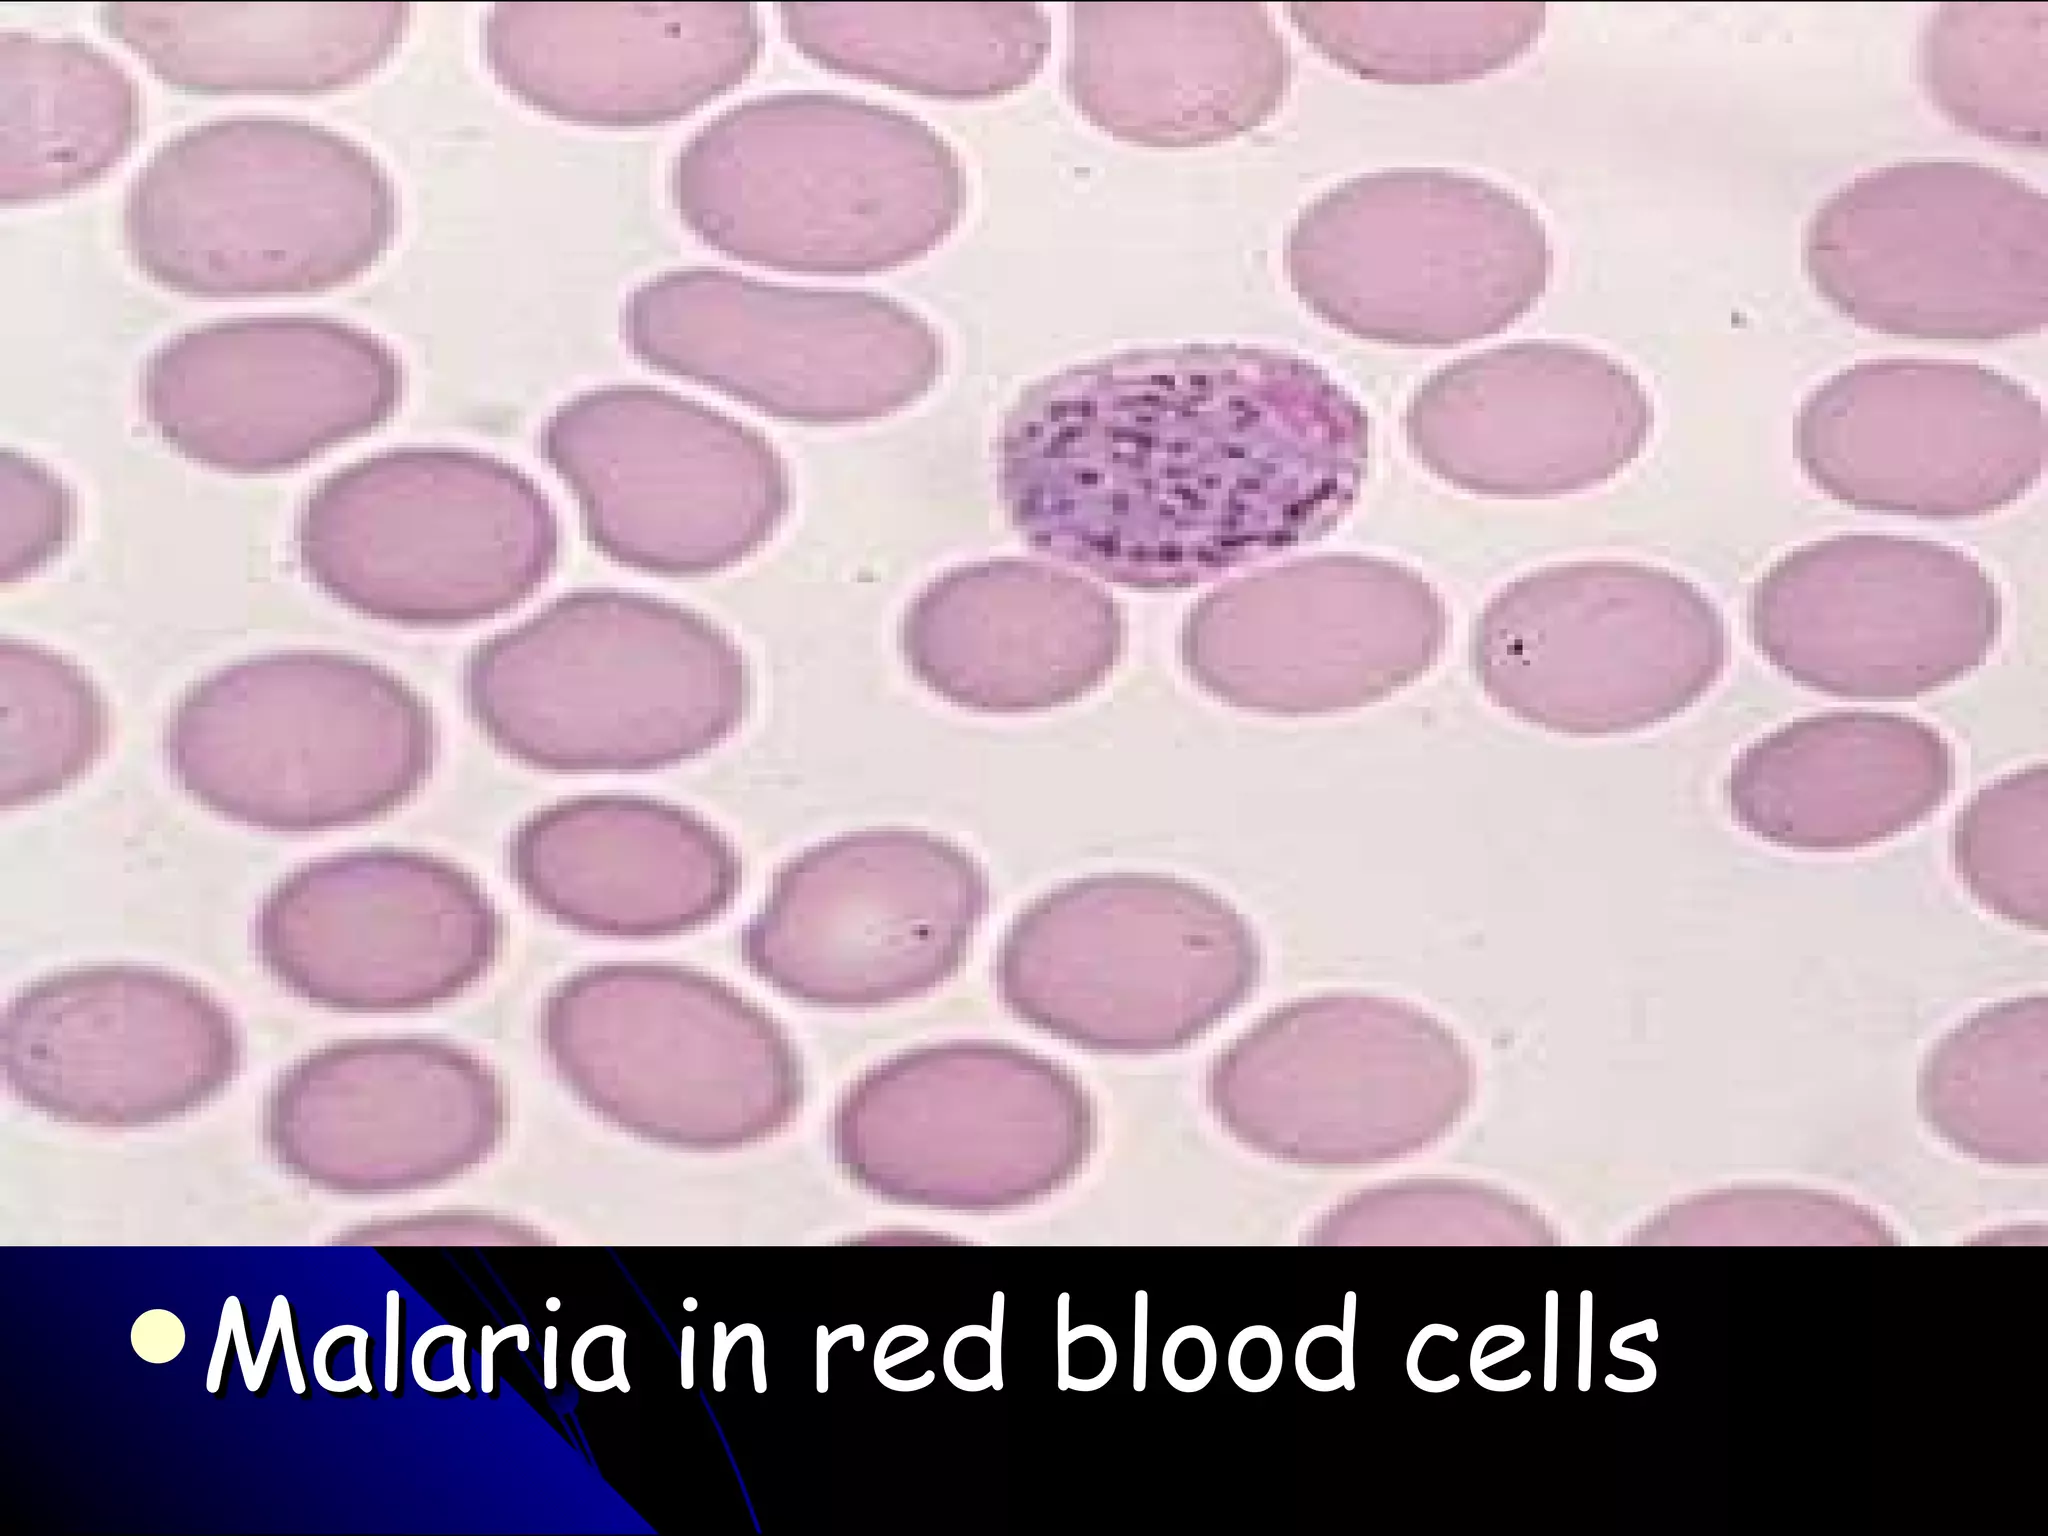
Malaria in red blood cells

The document discusses protists, which are eukaryotic organisms that are not plants, animals, or fungi. It describes how endosymbiotic theory explains the origins of organelles like mitochondria and chloroplasts from ancient prokaryotes. It then covers the four main groups of protists - protozoans, algae, fungi-like protists, and slime molds - and provides some examples of organisms from each group along with their characteristics.